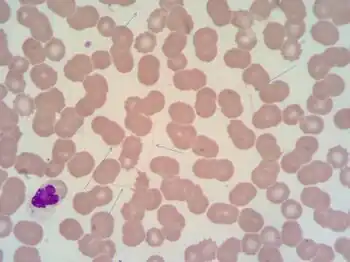

Borrelia recurrentis
| Borrelia recurrentis | |
|---|---|
![]() | |
| Photomicrographic view of a culture specimen showing Borrelia recurrentis bacteria | |
| Scientific classification | |
| Domain: | Bacteria |
| Phylum: | Spirochaetota |
| Class: | Spirochaetia |
| Order: | Spirochaetales |
| Family: | Borreliaceae |
| Genus: | Borrelia |
| Species: | B. recurrentis |
| Binomial name | |
| Borrelia recurrentis (Lebert, 1874) Bergey et al., 1925 | |
Borrelia recurrentis is a species of Borrelia, a spirochaete bacterium associated with relapsing fever.[1][2] B. recurrentis is usually transmitted from person to person by the human body louse.[3] Since the 1800s, the body louse has been known as its only known vector.[4]
B. recurrentis DNA was found in 23% of head lice from patients with louse-borne relapsing fever in Ethiopia. Whether head lice can transmit these bacteria from one person to another remains to be determined.[4]
It is notable for its ability to alter the proteins expressed on its surface, which causes the "relapsing" characteristic of relapsing fever.[5]
MGG stained thin film showing numerous spirochetes identified as Borrelia recurrentis
References
- ↑ Cutler SJ, Moss J, Fukunaga M, Wright DJ, Fekade D, Warrell D (October 1997). "Borrelia recurrentis characterization and comparison with relapsing-fever, Lyme-associated, and other Borrelia spp". International Journal of Systematic Bacteriology. 47 (4): 958–68. doi:10.1099/00207713-47-4-958. PMID 9336893.
- ↑ Meri T, Cutler SJ, Blom AM, Meri S, Jokiranta TS (July 2006). "Relapsing fever spirochetes Borrelia recurrentis and B. duttonii acquire complement regulators C4b-binding protein and factor H". Infection and Immunity. 74 (7): 4157–63. doi:10.1128/IAI.00007-06. PMC 1489703. PMID 16790790.
- ↑ Madigan, Michael T.; Martinko, John M. (2006). Brock biology of microorganisms. Upper Saddle River, NJ: Pearson Prentice Hall. p. 410. ISBN 0-13-144329-1.
- 1 2 Boutellis, A; Mediannikov, O; Bilcha, KD; Ali, J; Campelo, D; Barker, SC; et al. (2013). "Borrelia recurrentis in head lice, Ethiopia". Emerg Infect Dis. 19 (5): 796–798. doi:10.3201/eid1905.121480. PMC 3647509. PMID 23648147.
- ↑ Fisher, Bruce; Harvey, Richard P.; Strohl, William A.; Champe, Pamela C. (2007). Lippincott's Illustrated reviews, microbiology. Hagerstwon, MD: Lippincott Williams & Wilkins. pp. 166. ISBN 978-0-7817-8215-9.
This article is issued from Wmcloud. The text is licensed under Creative Commons - Attribution - Sharealike. Additional terms may apply for the media files.
